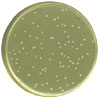

| Time (h): | 8 |
|---|---|
| O.D600 : | 3.8 | Viable Count: (click on the images to see the plate full-size and count the colonies) |
| 10-1 dilution: |  |
| 10-2 dilution: |  |
| 10-3 dilution: |  |
| 10-4 dilution: |  |
| 10-5 dilution: |  |
| 10-6 dilution: |  |
| Time (h): | 8 |
|---|---|
| O.D600 : | 3.8 | Viable Count: (click on the images to see the plate full-size and count the colonies) |
| 10-1 dilution: |  |
| 10-2 dilution: |  |
| 10-3 dilution: |  |
| 10-4 dilution: |  |
| 10-5 dilution: | |
| 10-6 dilution: |  |